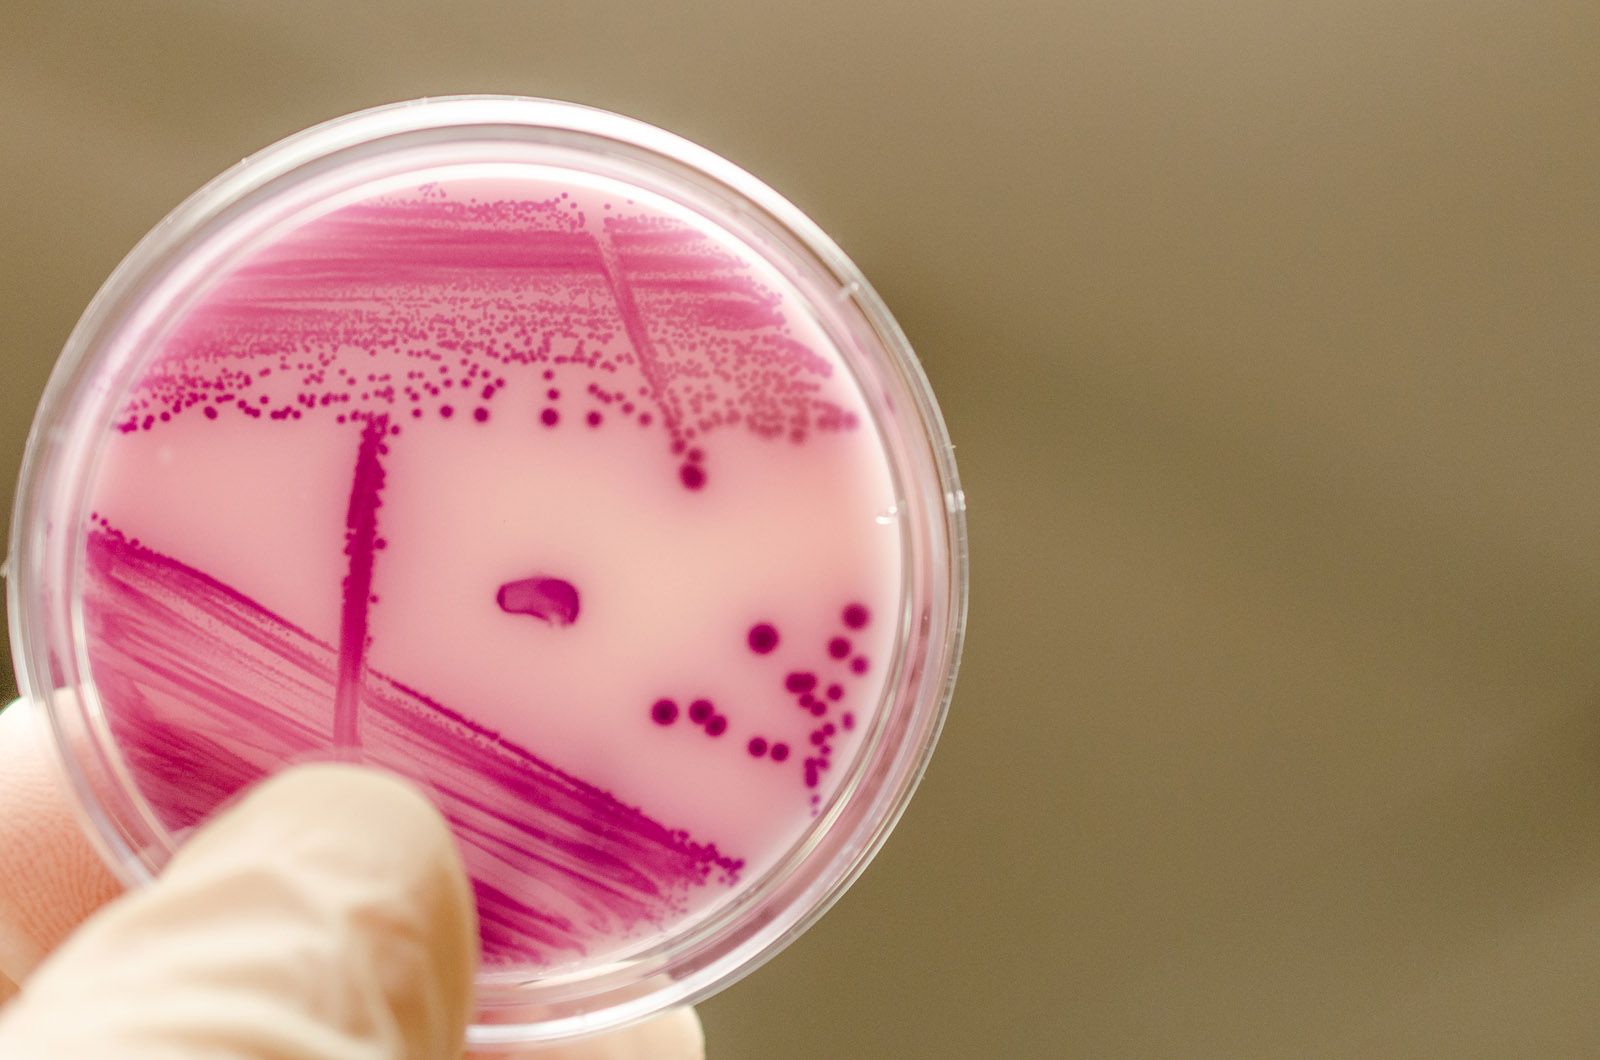
Descubren que la bacteria Escherichia coli podría contribuir al cáncer de intestino

Descubren que la bacteria 'Escherichia coli' podría contribuir al cáncer de intestino
El estudio ha dectado una toxina capaz de causar patrones o “huellas digitales” de daño en el ADN
La Escherichia coli (E. coli) es una bacteria que se encuentra en el intestino de los seres humanos y de los animales sanos. También está presente en el medio ambiente y en los alimentos. La mayoría de los tipos que hay no son perjudiciales, pero en ocasiones pueden hacer que enfermemos. En la mayoría de los casos cuando son dañinas generan diarrea, infecciones urinarias o sanguíneas, enfermedades respiratorias y otras patologías.
Las que causan trastornos suelen hacerlo a través del agua o alimentos contaminados y por el contacto entre personas y animales. Algunas de las que desencadenan diarreas son la E. coli productora de la toxina de Shiga (STEC) y la E. coli enterotoxigénica (ETEC).
Daños en el ADN
Recientemente un equipo de científicos de los Países Bajos, el Reino Unido y Estados Unidos, ha desarrollado una investigación para el Cancer Challenge UK Grand Challenge, que se ha publicado en la revista Nature, y en la que han descubierto una toxina que podría estar detrás del cáncer de intestino. En concreto, se trata de una toxina liberada por la cepa de E. coli y es capaz de causar patrones únicos o “huellas digitales” de daño en el ADN de las células que recubren el intestino. Dichas huellas se han encontrado también en los tumores de esta zona, comprobando por primera vez que hay un vínculo directo entre la toxina bacteriana y los cambios genéticos que acontecen durante el desarrollo del cáncer.
Los investigadores aseguran que con este descubrimiento y el daño específico que se hace al ADN en las células que recubren el intestino, constituiría una ayuda importante para identificar a personas con mayor riesgo de sufrir este tipo de cáncer y que además se utilizarían junto a las pruebas que ya existen para identificarlo.
Al mismo tiempo se piensa que otras toxinas presentes en el intestino podrían tener efectos similares, por lo que los estudios se están centrando en una búsqueda de estas, a la par que se trata de determinar si este mecanismo de daño de ADN se halla muy extendido.

Esta investigación en concreto se ha basado en una cepa de esta bacteria que produce colibactina, presente de forma habitual en las muestras de heces de personas con cáncer de intestino con respecto a las personas sanas. Desde el Instituto Hubrecht en los Países Bajos vieron que la colibactina puede causar daño al ADN en células cultivadas en el laboratorio. De modo que decidieron comprobar si esto sucedía también en las células de esta parte del aparato digestivo.
Para hacer la investigación emplearon réplicas en miniatura de un intestino humano creadas de forma artificial en el laboratorio. Los expusieron a este tipo de E. coli productora de colibactina y tras cinco meses de análisis encontraron el doble de daño en el ADN en comparación con los que no se habían sometido a esta variante de la bacteria intestinal sino a otra que no producía dicha sustancia.
Comparativas
Con los resultados obtenidos se realizaron comparativas con los datos de tumores de Reino Unido y de los Países Bajos. En las muestras holandesas se comprobó que las huellas digitales estaban en múltiples tumores, pero más a menudo en los cánceres de intestino que otros tipos. Mientras que en el Reino Unido, las huellas digitales de la colibactina estaban presentes en entre el 4 y 5% de los pacientes. Así, se desprende que esta bacteria podría contribuir a 1 de cada 20 casos de cáncer de intestino en este país.
Los científicos aseguran que es necesario seguir realizando más investigaciones, sobre todo para precisar el papel de la toxina en estos casos y ver qué otros componentes de la microbioma se pueden relacionar con las primeras etapas de esta clase de tumor.
“En la actualidad estamos buscando en otras bacterias y sus toxinas asociadas con el cáncer de intestino y esperamos identificar más huellas dactilares del daño del ADN para pintar una mejor imagen de los factores de riesgo”, ha matizado el profesor Philip Quirke, coinvestigador del Grand Challenge en la Universidad de Leeds.

Cáncer de intestino
La presencia de esta cepa tiene que ser sometida, por tanto, a una investigación más amplia para establecer qué papel juega en realidad en el cáncer. El de intestino es poco frecuente, sin embargo hay una serie de factores que pueden incrementar su riesgo. Entre ellos, mantener una dieta rica en grasas, la enfermedad de Crohn, la celiaquía y los antecedentes de pólipos en el colon.
Algunos de sus síntomas son dolor abdominal, la aparición de sangre en heces, la pérdida de peso sin razón aparente o el surgimiento de masas en la zona del abdomen. El diagnóstico por imagen en la zona del intestino delgado y sus alrededores ayuda a su detección y a comprobar si se ha diseminado. El tratamiento puede ser quirúrgico y mediante la aplicación de radioterapia, quimioterapia o una combinación de ambas.